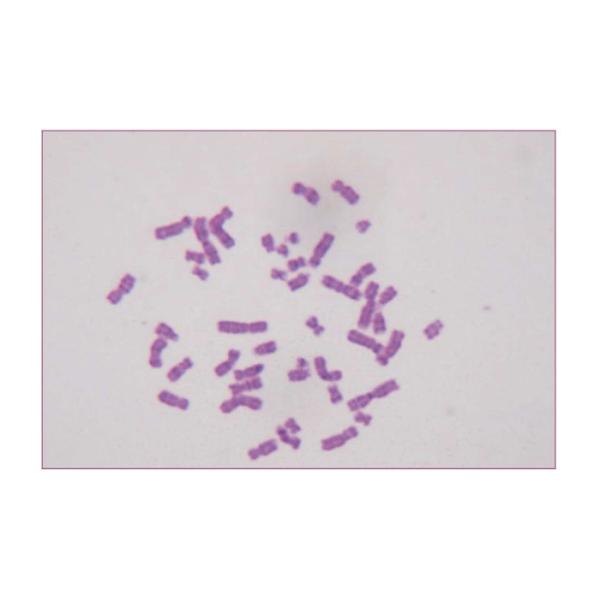

Giemsa Stain Baso Clear Colourful Stains Widely Used medical devices
Giemsa Stain

Intended Use:
This kit is for staining blood cell and chromosomes.
Principle:
Blood Cell Staining: Giemsa Stain is a mixture of methylene blue
and eosin.
Methylene blue is alkaline, and eosin is acid. Because each cell
and its components are different in chemical composition, their
affinities to acid stain and alkaline stain of this kit vary
significantly. Consequently, one can identify cells based on their
staining color, shape and other physical characteristics.
Methods:
Blood cell staining:
1. Dry the blood smear and fix in Methyl alcohol for 1~3 mins.
2. Place the fixed blood smear in diluted Giemsa stain(solution A: solution B= 1:9) for10~30mins.(Use drop
stain if specimens are not too many.) At lower room temperature in winter, incubate at 37℃.
3. Take out the slide and rinse with water. Dry the slide for microscopic examination.
Chromosome staining:
1. Pretreat the specimen with trypsin.
2. Dip the specimen into diluted Giemsa stain(solutionA: solution B=1:9) for 10 mins.
3. Rinse with water and examine under a microscope after drying the slide.
Specifications:
| Contents | Components | |
| Giemsa solution A | 1vial*100ml | Giemsa stain |
| Giemsa solution B | 4vials*250ml | Giemsa stain |
Expected Results:
Blood cell staining: Erythrocyte appears vermeil. Leukocyte appears varying shades of blue to dark blue. Structure of nuclei is clear.Cytoplasmic granules are stained clearly and appear the specific color of each cell.